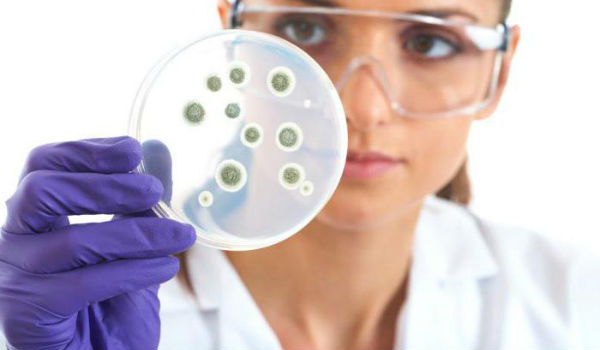

Гастрит, виразка, пульпіт – це захворювання, які дуже часто зустрічаються у людини. Препаратів для їх профілактики та запобігання існує теж чимало. Але одним з поширених питань є такою: Омез або Де-нол що краще. Саме ці медикаменти визнані найбільш ефективними при діагнозах, пов’язаних з захворюваннями ШКТ.

Зміст статті
- Відмінності препаратів
- Опис препарату омез
- Опис Де-нола
- Чи можна їх приймати одночасно
- Лікування хеликобакериоза
Відмінності препаратів
Головною відмінністю цих препаратів можна назвати те, що вони входять в різні фармологические групи. Діючою речовиною Омез можна назвати омепразол, коли у Де-нола це вісмут. У таблиці нижче будуть надані показання та протипоказання до цих препаратів.
Найчастіше Омез випускається у формі капсул, які необхідно ковтати, запиваючи великою кількістю води. Де-нол випускається у формі таблеток, для якнайшвидшого його впливу на організм потрібно приймати препарат за півгодини до їжі.

І, звичайно ж, головна відмінність цих двох засобів в ціні. Омез, дешевше Де-нола, саме тому дуже часто люди віддають перевазі цього медикаменту. Де-нол коштує близько 560 рублів за 58 таблеток, Омез ж дешевше – 170 рублів за тридцять капсул.
Важливо! Будь-яка людина має знати про те, що ці два препарати не є аналогами один одного. А тому, яким з них лікувати захворювання ШКТ може вирішити тільки лікар.
Омез підходить для зниження кислотності шлункового соку, а Де-нол найчастіше використовують для загоєння виразок, так як він володіє протизапальним ефектом.
То який з препаратів краще і ефективніше, вам відповість тільки лікар. Але головною перевагою Де-нола можна назвати антибактеріальну дію, чого не сказати про Омезе.

Опис препарату омез
Омез – це препарат, який зберігається в організмі людини протягом доби. Вміст капсул розчиняється в кишечнику, там воно ж і всмоктується. Дії, якими володіє препарат:
- в’яжучий;
- цитопротектиное;
- антибактеріальне;
- противиразкову;
- протимікробну.
Омез, також як і Де-нол може глибоко проникати у слизову і знищувати бактерії, які «селяться» на її оболонках. Омез або Омепрозол – це ефективні препарати для лікування захворювань шлунка. Однак у цих медикаментів є і аналог – Ультоп. Ультоп випускається не тільки в капсулах, але і у вигляді порошку для ін’єкцій, його ж, як і Де-нол можна використовувати в якості профілактики багатьох захворювань.
Багато людей все ж при виборі цих двох препаратів вибирають Ультоп, так як він набагато дешевше, адже перший препарат виготовляють в Португалії. Проте варто відзначити, що Омез – це один із сучасних препаратів в боротьбі з захворюваннями шлунково-кишкового тракту. Ультоп, на відміну від Денол і Омез має таке протипоказання: непереносимість цукрів.
Цей препарат ефективний тільки тому, що завдяки його прийому можна домогтися наступного:
- посилити ефект від прийому антибіотиків;
- знизити агресивність шлункового соку;
- швидко вивести з організму;
- не обмежувати людини в діяльності;
- у запущених стадіях може вводитися внутрішньовенно для швидкого проникнення всередину;
- добре переноситься людьми;
- приймається незалежно від прийому їжі, чого не сказати про лікування Де-нолом, запиваючи невеликою кількістю води.
Варто відзначити, що Омез ефективний не тільки при захворюваннях ШКТ, завдяки йому можна запобігти печію, вилікувати тяжкість живота після переїдання, усунути відрижку та інші несерйозні розлади з боку шлунка.
Тільки перед будь-яким лікуванням необхідно отримати консультацію лікаря, щоб не нашкодити своєму здоров’ю.
Опис Де-нола
Де-нол – це обов’язковий препарат, який повинен входити в комплексне лікування при гастриті, виразці шлунка та інших хворобах ШКТ. Цей препарат необхідний для того, щоб:
- загоювати виразки;
- зв’язувати жовчні кислоти;
- пригнічувати життя бактерій хелікобактер;
- сприяти вироблення слизу.

Незважаючи на те, що цей препарат діє як антибіотик, він практично нешкідливий і має мало протипоказань. Він не порушує мікрофлори, як інші засоби цього ряду, а також не викликає звикання і пристосовності бактерій. Може мати легкий запах аміаку, але більшість людей його просто не відчувають.
Варто знати, що більше 2 місяців лікуватися препаратами, що містять вісмут, не рекомендується. Важливо зробити перерву в лікуванні і поновити його тільки після консультації лікаря.
Чи можна їх приймати одночасно
Відповісти на питання що краще Де-нол або Омез дуже складно, так як вони надають різний вплив на організм людини. Тоді напрошується інше запитання: чи можна приймати ці засоби одночасно. На це питання можна отримати позитивну відповідь, так як при захворюваннях ШКТ важлива комплексна терапія. Омез є анисекреторным препаратом, який позитивно впливає на захворювання шлунку. Його основною дією можна назвати те, що після прийому даного медикаменту блокується внутрішньоклітинний фермент, який пригнічує шлункову секрецію.
Де-нол теж необхідний під час хвороб шлунка, так як після його прийому на слизовій внутрішніх органів утворюється захисна плівка, яка не дозволяє бактеріям хелікобактер розмножуватися. Це практично єдиний препарат, який може боротися з цими шкідливими бактеріями.
У тому випадку якщо хвороби проявляються з вираженою симптоматикою, то в обов’язковому порядку лікування потрібно проводити цими двома препаратами. Але як радять лікарі, то в один і той же час пити їх не рекомендується. Потрібно робити перерву в лікуванні. Якщо ж Омез і Де-нол разом приймаються, то другий препарат може стати неефективним, так як під час його прийняття 30 хвилин до і після не рекомендується нічого їсти і пити.

Багато людей вважають Омез антибіотиком, хоча насправді це не так. Він лише посилює дію антибактеріального препарату. Також потрібно не забувати про те, що, самостійно призначаючи собі терапію, ви можете спровокувати побічні ефекти і ускладнення.
Омез і Де-нол одночасно застосовувати можна, так як саме вони складають основу 3 або 4 компонентного лікування. Особливо таке лікування актуально при усуненні хронічних недуг. Якщо говорити про методи профілактики, то для цього більше підходить препарат Де-нол. Багато пацієнти бояться приймати за раз стільки медикаментів. Насправді для комплексної терапії підбираються безпечні ліки, які не чинять негативного впливу на організм людини.
Важливо! Вище вже говорилося про те, що приймати разом ці два препарати можна, але варто зазначити, що дуже часто тривалість їх прийому може відрізнятися. Тобто, коли ви закінчите лікування одним засобом, другим оздоровчу терапію продовжувати потрібно ще якийсь час.
Не варто перевищувати дозування, зазначеної лікарем при лікуванні захворювань ШЛУНКОВО-кишкового тракту. Так, наприклад, один препарат можна прийняти за годину до їжі, а другий через тридцять хвилин після прийняття їжі. Таке лікування повинно бути ефективним.
Лікування хеликобакериоза
Хелибактериоз – це одне з поширених захворювань, при якому ефективні ці кошти. Ці препарати хороші тим, що завдяки їм можна запобігти розмноження бактерії хелікобактер. Але досягти цього вдасться тільки в тому випадку, якщо приймати препарати за правильною схемою. Для лікування знадобиться як мінімум три препарату: антибіотики, антисекреторні засоби, гастроцитопротекторы.

Якщо ви приймаєте Омез, то його слід пити не менше двох разів на день за 20 мг. Де-нол ж можна приймати по 2 або по одній таблетці. Якщо ж ви вибрали по дві таблетки, то прийом такого засобу повинен проводитися двічі на день. За другою схемою частоту прийому потрібно збільшити до 4 разів.
Але варто пам’ятати про те, що як перший, так і другий препарат можуть викликати протипоказання і побічні ефекти. Якщо ж після прийому цих ліків відразу ж з’явилася нудота, запаморочення, блювота, то прийом засобу слід припинити і звернутися до лікаря.
Де-нол та омепразол — ефективні препарати при захворюваннях шлунка, які чудово доповнюють один одного. Лікуватися ними дозволено за схемою, прописаної лікарем і спостерігати за реакцією свого організму.


